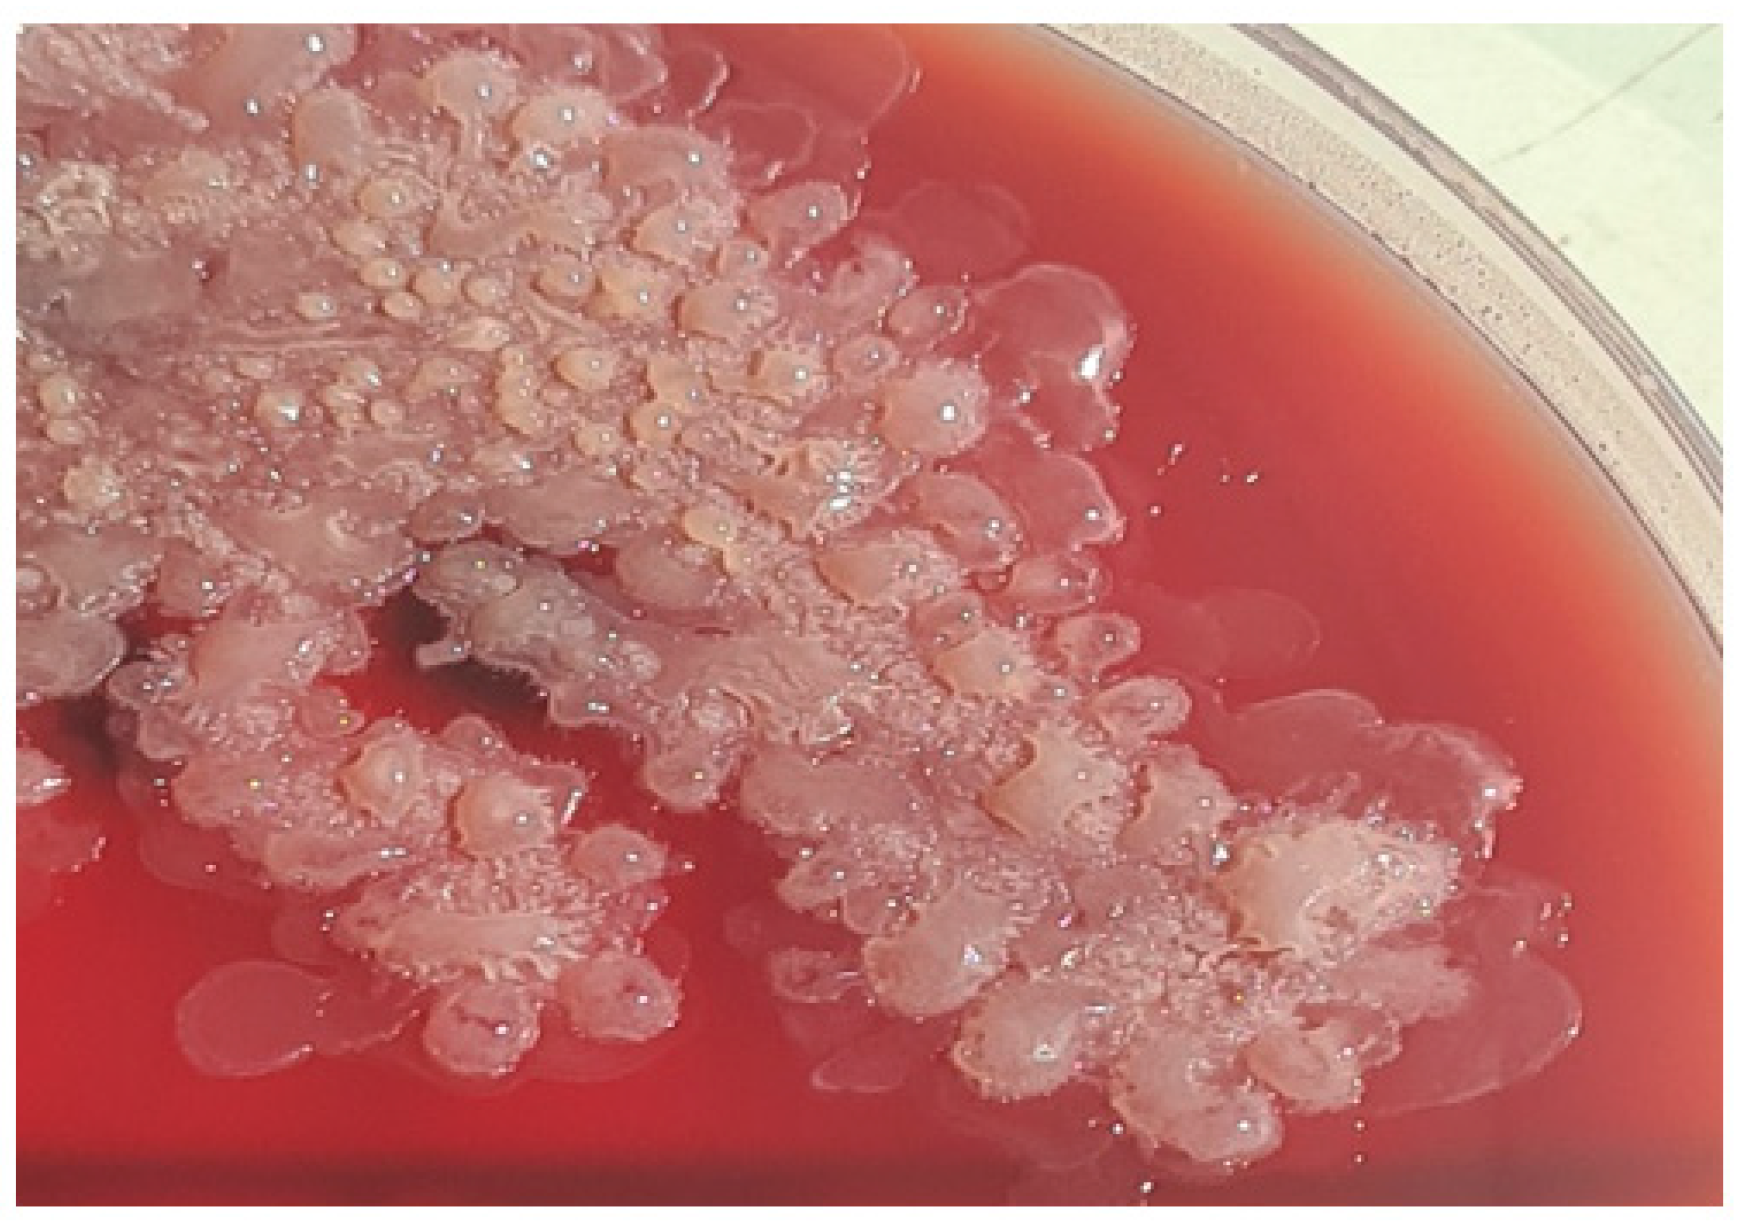
Antibiotics 11 00905 g003

A Rare Case of Endophthalmitis with Rhizobium radiobacter, Soon after a Resolved Keratitis: Case Report
Abstract
1. Introduction
2. Case Report
3. Systematic Review
4. Discussion
5. Conclusions
Author Contributions
Funding
Institutional Review Board Statement
Informed Consent Statement
Data Availability Statement
Acknowledgments
Conflicts of Interest
References
- Kowalski, R.P.; Nayyar, S.V.; Romanowski, E.G.; Shanks, R.M.Q.; Mammen, A.; Dhaliwal, D.K.; Jhanji, V. The Prevalence of Bacteria, Fungi, Viruses, and Acanthamoeba from 3004 Cases of Keratitis, Endophthalmitis, and Conjunctivitis. Eye Contact Lens 2020, 46, 265–268. [Google Scholar] [CrossRef] [PubMed]
- Helbig, H.; Noske, W.; Kleineidam, M.; Kellner, U.; Foerster, M.H. Bacterial Endophthalmitis after Anterior Chamber Paracentesis. Br. J. Ophthalmol. 1995, 79, 866. [Google Scholar] [CrossRef] [PubMed]
- Hoevenaars, N.E.D.; Gans, D.; Missotten, T.; van Rooij, J.; Lesaffre, E.; van Meurs, J.C. Suspected Bacterial Endophthalmitis Following Intravitreal Anti-VEGF Injection: Case Series and Literature Review. Ophthalmol. J. Int. D’ophtalmol. Int. J. Ophthalmol. Z. Augenheilkd. 2012, 228, 143–147. [Google Scholar] [CrossRef] [PubMed]
- Mishra, D.; Satpathy, G.; Chawla, R.; Venkatesh, P.; Ahmed, N.H.; Panda, S.K. Utility of Broad-Range 16S RRNA PCR Assay versus Conventional Methods for Laboratory Diagnosis of Bacterial Endophthalmitis in a Tertiary Care Hospital. Br. J. Ophthalmol. 2019, 103, 152–156. [Google Scholar] [CrossRef]
- Hsu, H.Y.; Lind, J.T.; Tseng, L.; Miller, D. Ocular Flora and Their Antibiotic Resistance Patterns in the Midwest: A Prospective Study of Patients Undergoing Cataract Surgery. Am. J. Ophthalmol. 2013, 155, 36–44.e2. [Google Scholar] [CrossRef]
- Shirodkar, A.R.; Pathengay, A.; Flynn, H.W.; Albini, T.A.; Berrocal, A.M.; Davis, J.L.; Lalwani, G.A.; Murray, T.G.; Smiddy, W.E.; Miller, D. Delayed- versus Acute-Onset Endophthalmitis after Cataract Surgery. Am. J. Ophthalmol. 2012, 153, 391–398.e2. [Google Scholar] [CrossRef]
- Haapala, T.T.; Nelimarkka, L.; Saari, J.M.; Ahola, V.; Saari, K.M. Endophthalmitis Following Cataract Surgery in Southwest Finland from 1987 to 2000. Graefe’s Arch. Clin. Exp. Ophthalmol. Albrecht Graefes Arch. Klin. Exp. Ophthalmol. 2005, 243, 1010–1017. [Google Scholar] [CrossRef]
- Ambiya, V.; Das, T.; Sharma, S.; Chhablani, J.; Dave, V.; Jalali, S.; Narayanan, R.; Joseph, J. Comparison of Clinico-Microbiological Profile and Treatment Outcome of in-House and Referred Post Cataract Surgery Endophthalmitis in a Tertiary Care Center in South India. J. Ophthalmic Inflamm. Infect. 2016, 6, 45. [Google Scholar] [CrossRef]
- Ness, T.; Kern, W.V.; Frank, U.; Reinhard, T. Postoperative Nosocomial Endophthalmitis: Is Perioperative Antibiotic Prophylaxis Advisable? A Single Centre’s Experience. J. Hosp. Infect. 2011, 78, 138–142. [Google Scholar] [CrossRef]
- Chiquet, C.; Aptel, F.; Combey-De Lambert, A.; Bron, A.M.; Campolmi, N.; Palombi, K.; Thuret, G.; Rouberol, F.; Cornut, P.L.; Creuzot-Garcher, C. Occurrence and Risk Factors for Retinal Detachment after Pars Plana Vitrectomy in Acute Postcataract Bacterial Endophthalmitis. Br. J. Ophthalmol. 2016, 100, 1388–1392. [Google Scholar] [CrossRef]
- Friling, E.; Montan, P. Bacteriology and Cefuroxime Resistance in Endophthalmitis Following Cataract Surgery before and after the Introduction of Prophylactic Intracameral Cefuroxime: A Retrospective Single-Centre Study. J. Hosp. Infect. 2019, 101, 88–92. [Google Scholar] [CrossRef] [PubMed]
- Ferrer, C.; Alio, J.; Rodriguez, A.; Andreu, M.; Colom, F. Endophthalmitis Caused by Fusarium Proliferatum. J. Clin. Microbiol. 2005, 43, 5372–5375. [Google Scholar] [CrossRef] [PubMed]
- McCannel, C.A. Meta-Analysis of Endophthalmitis after Intravitreal Injection of Anti-Vascular Endothelial Growth Factor Agents: Causative Organisms and Possible Prevention Strategies. Retina 2011, 31, 654–661. [Google Scholar] [CrossRef]
- Miller, J.J.; Scott, I.U.; Flynn, H.W.; Smiddy, W.E.; Murray, T.G.; Berrocal, A.; Miller, D. Endophthalmitis Caused by Bacillus Species. Am. J. Ophthalmol. 2008, 145, 883–888. [Google Scholar] [CrossRef] [PubMed]
- Pflugfelder, S.C.; Flynn, H.W.; Zwickey, T.A.; Forster, R.K.; Tsiligianni, A.; Culbertson, W.W.; Mandelbaum, S. Exogenous Fungal Endophthalmitis. Ophthalmology 1988, 95, 19–30. [Google Scholar] [CrossRef]
- Al-Torbak, A.A.; Al-Shahwan, S.; Al-Jadaan, I.; Al-Hommadi, A.; Edward, D.P. Endophthalmitis Associated with the Ahmed Glaucoma Valve Implant. Br. J. Ophthalmol. 2005, 89, 454–458. [Google Scholar] [CrossRef] [PubMed]
- Hatami, H.; Ghaffari Jolfayi, A.; Ebrahimi, A.; Golmohammadi, S.; Zangiabadian, M.; Nasiri, M.J. Contact Lens Associated Bacterial Keratitis: Common Organisms, Antibiotic Therapy, and Global Resistance Trends: A Systematic Review. Front. Ophthalmol. 2021, 1, 5. [Google Scholar] [CrossRef]
- Zhang, H.; Liu, Z. Endogenous Endophthalmitis: A 10-Year Review of Culture-Positive Cases in Northern China. Ocul. Immunol. Inflamm. 2010, 18, 133–138. [Google Scholar] [CrossRef]
- Regan, K.A.; Radhakrishnan, N.S.; Hammer, J.D.; Wilson, B.D.; Gadkowski, L.B.; Iyer, S.S.R. Endogenous Endophthalmitis: Yield of the Diagnostic Evaluation. BMC Ophthalmol. 2020, 20, 1–7. [Google Scholar] [CrossRef]
- Gajdzis, M.; Figuła, K.; Kamińska, J.; Kaczmarek, R. Endogenous Endophthalmitis—The Clinical Significance of the Primary Source of Infection. J. Clin. Med. 2022, 11, 1183. [Google Scholar] [CrossRef]
- Lai, C.C.; Teng, L.J.; Hsueh, P.R.; Yuan, A.; Tsai, K.C.; Tang, J.L.; Tien, H.F. Clinical and Microbiological Characteristics of Rhizobium Radiobacter Infections. Clin. Infect. Dis. 2004, 38, 149–153. [Google Scholar] [CrossRef] [PubMed]
- Chen, C.Y.; Hansen, K.S.; Hansen, L.K. Rhizobium Radiobacter as an Opportunistic Pathogen in Central Venous Catheter-Associated Bloodstream Infection: Case Report and Review. J. Hosp. Infect. 2008, 68, 203–207. [Google Scholar] [CrossRef] [PubMed]
- Paphitou, N.I.; Rolston, K.V.I. Catheter-Related Bacteremia Caused by Agrobacterium Radiobacter in a Cancer Patient: Case Report and Literature Review. Infection 2003, 31, 421–424. [Google Scholar] [CrossRef] [PubMed]
- Hanada, S.; Iwamoto, M.; Kobayashi, N.; Ando, R.; Sasaki, S. Catheter-Related Bacteremia Caused by Agrobacterium Radiobacter in a Hemodialysis Patient. Intern. Med. 2009, 48, 455–457. [Google Scholar] [CrossRef] [PubMed][Green Version]
- Miller, J.M.; Novy, C.; Hiott, M. Case of Bacterial Endophthalmitis Caused by an Agrobacterium Radiobacter-like Organism. J. Clin. Microbiol. 1996, 34, 3212–3213. [Google Scholar] [CrossRef]
- Doshi, R.R.; Leng, T.; Fung, A.E. Povidone-Iodine before Lidocaine Gel Anesthesia Achieves Surface Antisepsis. Ophthalmic Surg. Lasers Imaging 2011, 42, 346–349. [Google Scholar] [CrossRef] [PubMed]
- Friedman, D.A.; Mason, J.O.; Emond, T.; McGwin, G. Povidone-Iodine Contact Time and Lid Speculum Use during Intravitreal Injection. Retina 2013, 33, 975–981. [Google Scholar] [CrossRef]
- Avery, R.L.; Bakri, S.J.; Blumenkranz, M.S.; Brucker, A.J.; Cunningham, E.T.; D’amico, D.J.; Dugel, P.U.; Flynn, H.W.; Freund, K.B.; Haller, J.A.; et al. Intravitreal Injection Technique and Monitoring: Updated Guidelines of an Expert Panel. Retina 2014, 34 (Suppl. 12), S1–S18. [Google Scholar] [CrossRef]
- Donzis, P.B.; Mondino, B.J.; Weissman, B.A.; Bruckner, D.A. Microbial Contamination of Contact Lens Care Systems. Am. J. Ophthalmol. 1987, 104, 325–333. [Google Scholar] [CrossRef]
- Clark, B.J.; Harkins, L.S.; Munro, F.A.; Devonshire, P. Microbial Contamination of Cases Used for Storing Contact Lenses. J. Infect. 1994, 28, 293–304. [Google Scholar] [CrossRef]
- Romano, L.; Spanu, T.; Calista, F.; Zappacosta, B.; Mignogna, S.; Sali, M.; Fiori, B.; Fadda, G. Tsukamurella Tyrosinosolvens and Rhizobium Radiobacter Sepsis Presenting with Septic Pulmonary Emboli. Clin. Microbiol. Infect. 2011, 17, 1049–1052. [Google Scholar] [CrossRef]
- Miño De Kaspar, H.; Grasbon, T.; Kampik, A. Automated Surgical Equipment Requires Routine Disinfection of Vacuum Control Manifold to Prevent Postoperative Endophthalmitis. Ophthalmology 2000, 107, 685–690. [Google Scholar] [CrossRef]
- Rohowetz, L.J.; Yannuzzi, N.A.; Gupta, S.; Patel, N.A.; Miller, D.; Flynn, H.W. Endophthalmitis Caused by Agrobacterium Radiobacter Following Intravitreal Aflibercept for Diabetic Retinopathy. Case Rep. Ophthalmol. 2020, 11, 22–27. [Google Scholar] [CrossRef] [PubMed]
- Rohowetz, L.J.; Patel, N.A.; Quan, A.V.; Fan, K.C.; Yannuzzi, N.A.; Reyes-Capó, D.P.; Laura, D.; Ansari, Z.A.; Patel, U.; Dubovy, S.R.; et al. Agrobacterium Radiobacter Endophthalmitis Associated with Baerveldt Tube Exposure. Case Rep. Ophthalmol. 2021, 12, 921–926. [Google Scholar] [CrossRef]
- Barker, N.H.; Thompson, J.M.; Mullen, M.G.; Weekes, M.A.; Nguyen, L.N.; Haynes, C.K.M.; Miller, D. Rhizobium Radiobacter: A Recently Recognized Cause of Bacterial Keratitis. Cornea 2016, 35, 679–682. [Google Scholar] [CrossRef] [PubMed]
- Fenner, B.J.; Kumar, A.; Tan, N.Y.Q.; Ang, M. Case of Isolated Rhizobium Radiobacter Contact Lens-Related Infectious Keratitis: A Plant Microbe Now Emerging as a Human Pathogen. Am. J. Ophthalmol. Case Rep. 2019, 15, 100476. [Google Scholar] [CrossRef]
- Al-Abdullah, A.A.; Al-Falah, M.; Al-Rashaed, S.; Khandekar, R.; Arevalo, J.F. Endophthalmitis Caused by Rhizobium Radiobacter After Posterior Chamber Phakic Intraocular Lens Implantation to Correct Myopia. J. Refract. Surg. 2015, 31, 561–563. [Google Scholar] [CrossRef]
- CLSI. Performance Standards for Antimicrobial Susceptibility Testing, 30th ed.; CLSI supplement M100; Clinical Laboratory Standards Institute: Wayne, PA, USA, 2020. [Google Scholar]
- Harbiyeli, I.I.; Oruz, O.; Erdem, E.; Cam, B.; Demirkazik, M.; Acikalin, A.; Kibar, F.; Ilkit, M.; Yarkin, F.; Yagmur, M. Clinical Aspects and Prognosis of Polymicrobial Keratitis Caused by Different Microbial Combinations: A Retrospective Comparative Case Study. Int. Ophthalmol. 2021, 41, 3849–3860. [Google Scholar] [CrossRef]
- Tellegen, E.; ter Riet, G.; Sloos, J.H.; van Weert, H.C.P.M. Diagnosis of Conjunctivitis in Primary Care: Comparison of Two Different Culture Procedures. J. Clin. Pathol. 2009, 62, 939–941. [Google Scholar] [CrossRef]
- Chiquet, C.; Maurin, M.; Thuret, G.; Benito, Y.; Cornut, P.L.; Creuzot-Garcher, C.; Rouberol, F.; Pechinot, A.; Lina, G.; Romanet, J.P.; et al. Analysis of Diluted Vitreous Samples from Vitrectomy Is Useful in Eyes with Severe Acute Postoperative Endophthalmitis. Ophthalmology 2009, 116, 2437–2441. [Google Scholar] [CrossRef]
- Namdari, H.; Hamzavi, S.; Peairs, R.R. Rhizobium (Agrobacterium) Radiobacter Identified as a Cause of Chronic Endophthalmitis Subsequent to Cataract Extraction. J. Clin. Microbiol. 2003, 41, 3998–4000. [Google Scholar] [CrossRef] [PubMed]
- Lautrop, H. Agrobacterium spp. Isolated from Clinical Specimens. Acta Pathol. Microbiol. Scand. Suppl. 1967, 187, 63–64. [Google Scholar]
- Plotkin, G.R. Agrobacterium Radiobacter Prosthetic Valve Endocarditis. Ann. Intern. Med. 1980, 93, 839–840. [Google Scholar] [CrossRef] [PubMed]
- Joshi, L.; Morarji, J.; Tomkins-Netzer, O.; Lightman, S.; Taylor, S.R.J. Rhizobium Radiobacter Endophthalmitis Following Intravitreal Ranibizumab Injection. Case Rep. Ophthalmol. 2012, 3, 283–285. [Google Scholar] [CrossRef] [PubMed]

| Endophthalmitis Type | Etiology | Recommended Intravitreal Treatment | Recommended Systemic Antibiotics |
|---|---|---|---|
| After cataract surgery | Staphylococcus epidermidis, Staphylococcus warneri, Staphylococcus capitis, Staphylococcus haemolyticus, Staphylococcus aureus, Propionibacterium acnes, Streptococcus pneumoniae, Streptococcus agalactiae, Streptococcus intermedius, Abiotrophia defectiva, Bacillus cereus, Pseudomonas aeruginosa, Pseudomonas stutzeri, Klebsiella pneumoniae, Haemophilus influenzae, Acinetobacter baumannii, Agrobacterium tumefaciens, Citrobacter freundii, Rhizobium radiobacter, Escherichia coli, Enterococcus faecalis, Stenotrophomonas maltophilia, Mycobacterium chelonae, Propionibacterium acnes (in chronic cases), fungi (Candida albicans, Candida parapsilosis, Acremonium strictum, Aspergillus fumigatus, Paecilomyces variotti, Fusarium proliferatum) [5,6,7,8,9,10,11,12] | Vancomycin, ceftazidime | Rarely used (in severe cases) |
| After intravitreal injections | Staphylococcus aureus, Streptococcus viridans, Streptococcus mitis, Streptococcus viridans, Enterococcus faecalis [3,13] | Vancomycin, ceftazidime | Quinolones (moxifloxacin) |
| After eye traumatism | Staphylococcus aureus, S. epidermidis, S. capitis, Staphylococcus warneri, S. pasteuri, S. auricularis, S. piscifermentans, S. lugdunensis, Streptococcus mutans, S. salivarium, S. mutans, S. oralis, S. sanguinis, S. vestibularis, S. termophilus, Enterococcus faecalis, Rhizobium radiobacter, Bacillus cereus, Escherichia coli, Candida parapsilosis, Candida albicans, Candida glabrata, Candida famata, Aspergillus flavus, Acremonium curvulum, Fusarium solani, Fusarium proliferatum) [10,14,15] | Vancomycin, ceftazidime, amphotericin (if suspicion of fungal infection) | Vancomycin, ceftazidime, ciprofloxacin |
| After Baerveldt tube exposure (in glaucoma treatment) | Haemophilus influenzae, Streptococcus pneumoniae, Streptococcus agalactia, Streptococcus mitis, Corynebacterium spp., Pseudomonas aeruginosa, Aspergillus flavus, Aspergillus fumigatus [16] | Aancomycin, ceftazidime | Rarely used |
| After long-term wear of contact lenses | Pseudomonas aeruginosa, Serratia marcescens, Staphylococcus epidermidis, Staphylococcus aureus, Streptococcus mitis, Streptococcus salivarium, Streptococcus mutans, Streptococcus pneumoniae, Klebsiella oxytoca, Enterobacter cloacae, Propionibacterium acnes [17] | Aminoglycosides, fluoroquinolones, 3rd-generation cephalosporins, vancomycin | Rarely used |
| Endogenous endophthalmitis | Staphylococcus aureus, Staphylococcus epidermidis, Staphylococcus lugdunensis, Streptococcus viridans, Streptococcus pyogenes, Streptococcus agalactiae, Streptococcus pneumoniae, Enterococcus faecalis, Escherichia coli, Klebsiella pneumoniae, Serratia marcescens, Kingella kingae, Pseudomonas aeruginosa, (Candida albicans, Candida parapsilosis, Candida glabrata, Aspergillus flavus, Aspergillus fumigatus) [18,19,20] | Vancomycin, ceftazidime (or amikacin) | Antibiotics according to etiology |
| Authors | Journal | Title | Article Type | No. of Samples/Patients | Mean Age (Years) | Pre-Existent Eye Conditions | Eye Trauma | Antibiotic Susceptibility Results | Drug Therapy | Outcome |
|---|---|---|---|---|---|---|---|---|---|---|
| Rohowetz et al. (2020) [33] | Case Reports in Ophthalmology | Endophthalmitis Caused by Agrobacterium radiobacter Following Intravitreal Aflibercept for Diabetic Retinopathy | Case report | 1 | 79 | Diabetic retinopathy | Intravitreal aflibercept | - | Intravitreal vancomycin and azithromycin; oral gentamicin and levofloxacin | Infection resolved |
| Rohowetz et al. (2021) [34] | Case Reports in Ophthalmology | Agrobacterium radiobacter Endophthalmitis Associated with Baerveldt Tube Exposure | Case report | 1 | 85 | Angle-closure glaucoma | Baerveldt tube insertion | Resistance to cefazolin, ceftazidime, amikacin, tobramycin, and trimethoprim–sulfamethoxazole | Injection of intravitreal vancomycin (1 mg) and ceftazidime (2.25 mg). Drops of 0.5% moxifloxacin every 2 h. Injection of 0.2 mg of intravitreal gentamicin | Visual acuity improvement after 2 weeks and then lost to follow-up |
| Barker et al. (2016) [35] | Cornea | Rhizobium radiobacter: A Recently Recognized Cause of Bacterial Keratitis | Case series | 4 | 26 | None identified | Cement-splash injury | Susceptibility to ciprofloxacin and minocycline | Moxifloxacin drops. Oral ketoconazole. Ciprofloxacin drops hourly and oral ciprofloxacin (250 mg) twice daily | Infection resolved |
| 26 | Contact lens wearer | - | Ciprofloxacin, ceftazidime, levofloxacin, minocycline. Resistant to trimethoprim–sulfamethoxazole | Drops with vancomycin and tobramycin. Vancomycin dropped and ciprofloxacin added | Infection resolved | |||||
| 19 | Contact lens wearer | Corneal ulcer | Susceptibility to gentamicin, ciprofloxacin, levofloxacin, ceftazidime, and polymyxin | Ofloxacin, tobramycin and cefazolin. Cyclopentolate 3 times daily. Prednisolone 1% | Infection resolved with a residual scar | |||||
| 19 | Contact lens wearer | - | Susceptibility to gentamicin, ceftazidime, amikacin, and polymyxin | Oral acyclovir 400 mg and gatifloxacin twice daily. Scopolamine 3 times daily | Lost to follow-up | |||||
| Fenner et al. (2019) [36] | American Journal of Ophthalmology Case Reports | Case of Isolated Rhizobium radiobacter Contact-Lens-Related Infectious Keratitis: A Plant Microbe Now Emerging as a Human Pathogen | Case report | 1 | 26 | Contact lens wearer | - | Susceptibility to cefepime, ciprofloxacin, and gentamicin | Hourly cefazolin (50 mg/mL) and gentamicin (14 mg/mL). Hourly 0.02% chlorhexidine. Hourly 1.5% levofloxacin, hourly cefazolin, and two-hourly chlorhexidine to both eyes during waking hours, and 0.3% ciprofloxacin ointment overnight. Levofloxacin 1.5% monotherapy for both eyes at four weeks | Favorable evolution with central anterior-to-mid-stromal scar |
| Al-Abdullah et al. (2015) [37] (no full text available) | Journal of Refractive Surgery | Endophthalmitis Caused by Rhizobium radiobacter After Posterior Chamber Phakic Intraocular Lens Implantation to Correct Myopia | Case report | 1 | 29 | Myopia | Posterior chamber phakic intraocular lens implantation | - | Intravitreal injections of vancomycin and ceftazidime | Infection resolved |
| Mishra et al. (2019) [4] | The British Journal of Ophthalmology | Utility of Broad-Range 16S rRNA PCR Assay Versus Conventional Methods for Laboratory Diagnosis of Bacterial Endophthalmitis in a Tertiary Care Hospital | Research article | 8 out of 195 vitreous aspirates from endophthalmitis patients | - | - | Cataract surgery | Susceptible to all tested antibiotics (according to document M45 of CLSI 2010 [38]) | - | - |
| Shirodokar et al. (2012) [6] | American Journal of Ophthalmology | Delayed- Versus Acute-Onset Endophthalmitis after Cataract Surgery | Research article | 1 out of 119 patients with endophthalmitis | - | - | Cataract surgery | - | - | - |
| Hsu et al. (2013) [5] | American Journal of Ophthalmology | Ocular Flora and their Antibiotic Resistance Patterns in the Midwest: A Prospective Study of Patients Undergoing Cataract Surgery | Research article | 1 out of 183 conjunctival cultures | - | - | Cataract surgery | Susceptible to cefazolin, ceftazidime, gentamycin, tobramycin, amikacin, ciprofloxacin, and levofloxacin | - | - |
| Harbiyeli et al. (2021) [39] | International Ophthalmology | Clinical Aspects and Prognosis of Polymicrobial Keratitis Caused by Different Microbial Combinations: A Retrospective Comparative Case Study | Research article | 1 out of 44 corneal scrapings | - | Polymicrobial keratitis | - | Susceptible to ciprofloxacin and moxifloxacin | - | - |
| Haapala et al. (2005) [7] | Graefe’s Archive for Clinical and Experimental Ophthalmology | Endophthalmitis Following Cataract Surgery in Southwest Finland from 1987 to 2000 | Research article | 1 out of 47 patients | - | - | Postoperative endophthalmitis after cataract surgery | - | - | - |
| Tellegen et al. (2009) [40] | Journal of Clinical Pathology | Diagnosis of Conjunctivitis in Primary Care: Comparison of Two Different Culture Procedures | Research article | 1 out of 88 patients | - | Infectious conjunctivitis | - | - | - | - |
| Chiquet et al. (2016) [10] | The British Journal of Ophthalmology | Occurrence and Risk Factors for Retinal Detachment after Pars Plana Vitrectomy in Acute Post-Cataract Bacterial Endophthalmitis | Research article | 1 out of 123 vitreous aspirates | - | - | Post-cataract bacterial endophthalmitis treated with pars plana vitrectomy | - | - | - |
| Ambiya et al. (2016) [8] | Journal of Ophthalmic Inflammation and Infection | Comparison of Clinico-Microbiological Profile and Treatment Outcome of In-House and Referred Post-Cataract-Surgery Endophthalmitis in a Tertiary Care Center in South India | Research article | 1 out of 100 patients | Cataract surgery | Susceptible to amikacin, ceftazidime, gatifloxacin, moxifloxacin, ciprofloxacin, and ofloxacin. Resistant to chloramphenicol | Intraocular antibiotics (1 mg of vancomycin in 0.1 mL of normal saline; 2.25 mg of ceftazidime in 0.1 mL of normal saline). Intravitreal dexamethasone (0.4 mg in 0.1 mL). Topical 1% prednisolone acetate (every 4 h). Cycloplegia. Systemic ciprofloxacin (1500 mg/day in two divided doses) | - | ||
| Ness et al. (2011) [9] | The Journal of Hospital Infection | Postoperative Nosocomial Endophthalmitis: Is Perioperative Antibiotic Prophylaxis Advisable? A Single Centre’s Experience | Research article | 1 out of 16 patients with endophthalmitis | - | - | Cataract surgery | Susceptibility to gentamicin, ciprofloxacin, and ofloxacin | - | - |
| Chiquet et al. (2009) [41] | Ophthalmology | Analysis of Diluted Vitreous Samples from Vitrectomy is Useful in Eyes with Severe Acute Postoperative Endophthalmitis | Research article | 1 out of 34 patients with endophthalmitis | - | Diabetes mellitus immunosuppression | Cataract surgery | - | - | - |
| Friling (2019) [11] | The Journal of Hospital Infections | Bacteriology and Cefuroxime Resistance in Endophthalmitis Following Cataract Surgery before and after the Introduction of Prophylactic Intracameral Cefuroxime: A Retrospective Single-Centre Study | Research article | 3 out of 95 patients with endophthalmitis | - | - | Cataract surgery | - | Intravitreal injection of 1 mg of cefuroxime; 2.27 mg of ceftazidime and 1 mg of vancomycin. Oral dose of prednisone (60 mg for five days) | - |
| Namdari et al. (2003) [42] | Journal of Clinical Microbiology | Rhizobium (Agrobacterium) radiobacter Identified as a Cause of Chronic Endophthalmitis Subsequent to Cataract Extraction | Case report | 1 | 62 | Uncomplicated cataract extraction | - | Susceptibility to ciprofloxacin, resistance to ceftazidime and vancomycin | Intravitreal injection of amikacin (0.4 mg) and vancomycin (1 mg). Intravitreal administration of gentamicin (0.4 mg). Oral ciprofloxacin (500 mg twice daily for 10 days) | Infection resolved |
Publisher’s Note: MDPI stays neutral with regard to jurisdictional claims in published maps and institutional affiliations. |
© 2022 by the authors. Licensee MDPI, Basel, Switzerland. This article is an open access article distributed under the terms and conditions of the Creative Commons Attribution (CC BY) license (https://creativecommons.org/licenses/by/4.0/).
Share and Cite
Balasoiu, A.T.; Zlatian, O.M.; Ghenea, A.E.; Davidescu, L.; Lungu, A.; Golli, A.L.; Udriștoiu, A.-L.; Balasoiu, M. A Rare Case of Endophthalmitis with Rhizobium radiobacter, Soon after a Resolved Keratitis: Case Report. Antibiotics 2022, 11, 905. https://doi.org/10.3390/antibiotics11070905
Balasoiu AT, Zlatian OM, Ghenea AE, Davidescu L, Lungu A, Golli AL, Udriștoiu A-L, Balasoiu M. A Rare Case of Endophthalmitis with Rhizobium radiobacter, Soon after a Resolved Keratitis: Case Report. Antibiotics. 2022; 11(7):905. https://doi.org/10.3390/antibiotics11070905
Chicago/Turabian StyleBalasoiu, Andrei Theodor, Ovidiu Mircea Zlatian, Alice Elena Ghenea, Livia Davidescu, Alina Lungu, Andreea Loredana Golli, Anca-Loredana Udriștoiu, and Maria Balasoiu. 2022. "A Rare Case of Endophthalmitis with Rhizobium radiobacter, Soon after a Resolved Keratitis: Case Report" Antibiotics 11, no. 7: 905. https://doi.org/10.3390/antibiotics11070905
APA StyleBalasoiu, A. T., Zlatian, O. M., Ghenea, A. E., Davidescu, L., Lungu, A., Golli, A. L., Udriștoiu, A.-L., & Balasoiu, M. (2022). A Rare Case of Endophthalmitis with Rhizobium radiobacter, Soon after a Resolved Keratitis: Case Report. Antibiotics, 11(7), 905. https://doi.org/10.3390/antibiotics11070905

